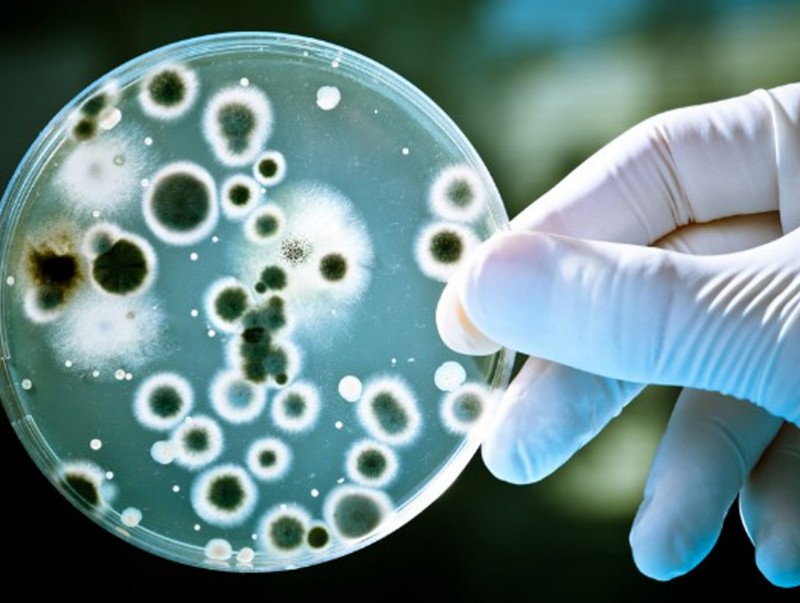

Бичил биетний тэсвэржилтийн талаарх мэдлэгийг дээшлүүлэх 7 хоног болж байна
МОНГОЛЫН МЭДЭЭ | НИЙГЭМ
Улаанбаатар, 2025 оны арваннэгдүгээр сарын 18 /МОНЦАМЭ/. Дэлхий нийтээрээ “Бичил биетний тэсвэржилтийн талаарх мэдлэг, хандлагыг дээшлүүлэх 7 хоног”-ийг тэмдэглэж байна.
Дэлхий дахинд жил бүрийн 11 дүгээр сарын 18-24-ний өдрүүдэд бичил биетний тэсвэржилтийн талаарх хүн
амын мэдлэг боловсролыг нэмэх, бодлогын
өөрчлөлт, нэн шаардлагатай арга хэмжээг уриалах, “Нэг эрүүл мэнд”-ийн зарчмаар бүх салбарын хамтын ажиллагааг
бэхжүүлэх, Монгол Улс бичил
биетний эсрэг эмийг хүн, мал амьтан, газар тариалангийн салбарт буруу, зохисгүй
хэрэглэхээс урьдчилан
сэргийлэх, тэсвэржилтээс хамгаалах арга хэмжээг өрнүүлдэг байна.
Эрүүл мэнд, Байгаль орчин, Хүнс, хөдөө аж ахуйн асуудал эрхэлсэн байгууллагууд ДЭМБ, НҮБ-ын ХХААБ, Мал амьтны эрүүл мэндийн байгууллага хамтран энэ жил 11 дэх удаагаа зохион байгуулахаар нээлтээ хийжээ.


Связанные новости


 Ulaanbaatar
Ulaanbaatar











































































